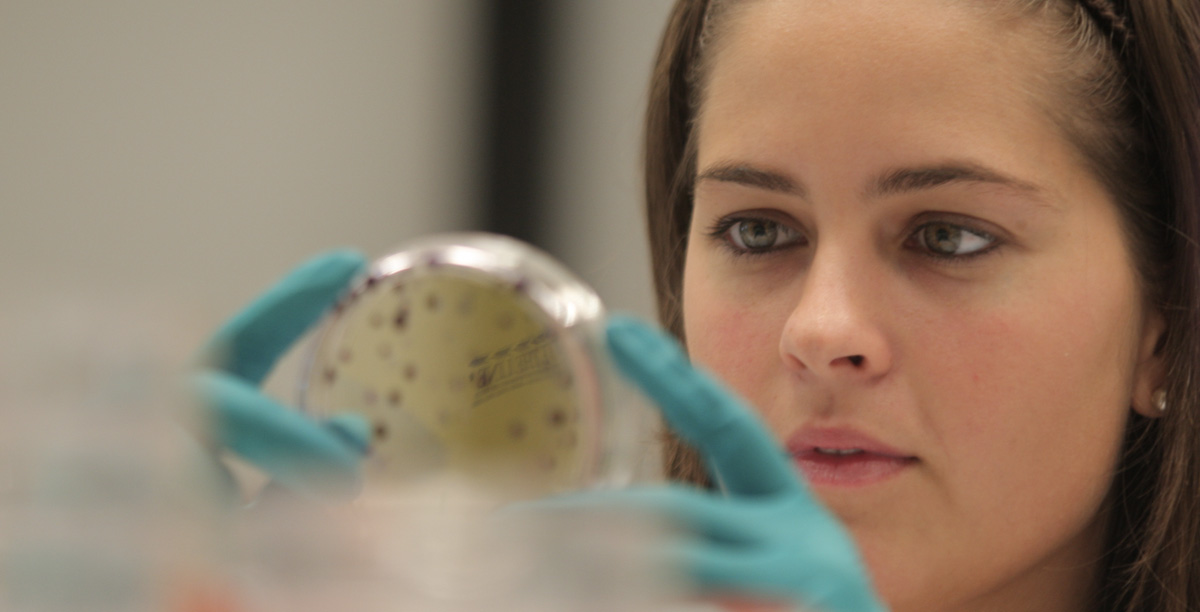

Objetivos
El principal objetivo de este módulo es introducir el vasto campo de las bases de la investigación de diseño epidemiológico. Por el uso posterior que tendrá en el desarrollo de los demás módulos clínicos y prácticos del Programa, cobra especial interés el aprendizaje de los diseños de la investigación clínica y las posibles falacias de la investigación: sesgos y confusión.
Programa
1) El método epidemiológico.
2) Estimación del tamaño muestral.
3) Medidas de frecuencia.
4) Medidas de asociación.
5) Medidas de impacto potencial.
6) Errores y sesgos en epidemiología.
7) Estudios transversales y ecológicos.
8) Estudios de cohortes.
9) Estudios de casos y controles.
10) Estudios experimentales.
Asignatura
En el siguiente enlace se puede encontrar información más detallada acerca de la asignatura Epidemiología.
Dra. Silvia Carlos Chillerón
Profesora Encargada
scarlos@unav.esEdificio de Investigación
C/ Irunlarrea, s/n
31008 Pamplona, España
Tel. (+34) 948 42 56 00
Ext. 806636